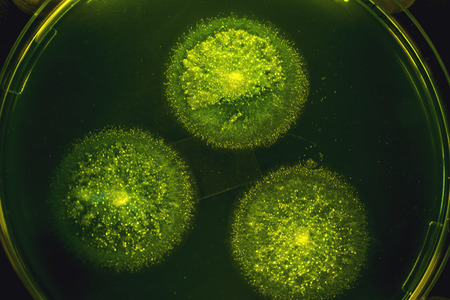
Beautiful colorful bacterial culture in petri dish laboratory fungus and bacteriaの写真素材

写真素材 - Beautiful colorful bacterial culture in petri dish laboratory fungus and bacteria
作品情報
Beautiful colorful bacterial culture in petri dish laboratory fungus and bacteria
- ID:91121572
- 作品種別:写真
- 作者名:Iliescu Catalin
キーワード
- agar
- analysis
- assay
- background
- bacteria
- bacterium
- biochemistry
- biology
- biotechnology
- care
- chemistry
- colonies
- culture
- dish
- dishes
- equipment
- experiment
- fungus
- glass
- hand
- health
- healthcare
- isolated
- lab
- laboratory
- medical
- medicine
- microbe
- microbiology
- microscope
- mold
- mycology
- petri
- plate
- red
- research
- sample
- science
- scientific
- technology
- test
- white
- yellow
類似作品
Diverse colorfu...
Bacteria and vi...
Jelly gummy wor...
Microscopic Vie...
microorganism c...
Bacteria moving...
Diverse colorfu...
Vibrant 3D rend...
Mixed of bacter...
Abstract bright...
3d abstract com...
Threads of fung...
Digital germs m...
Diverse colorfu...
A close up of a...
Vivid Connectiv...
Discover the in...
Visualization o...
Diverse colorfu...
Dynamic motion ...
This striking i...
Close-up of ger...
Close up view r...
3d illustration...
Microscopic Vie...
Close up examin...
microorganism c...
This vibrant il...
This vibrant il...
Vivid Represent...
Close-up of bac...
a close up of b...
Exploring the m...
Viruses in the ...
Vibrant coral p...
This vibrant il...
Diverse colorfu...
High-res image ...
Bacteria cells ...
Close up of col...
Explore a stunn...
Colorful and in...
close-up of col...
A stunning clos...
Bacteria of dif...
Colorful depict...
High-definition...
Colorful bacter...
Macro close up ...